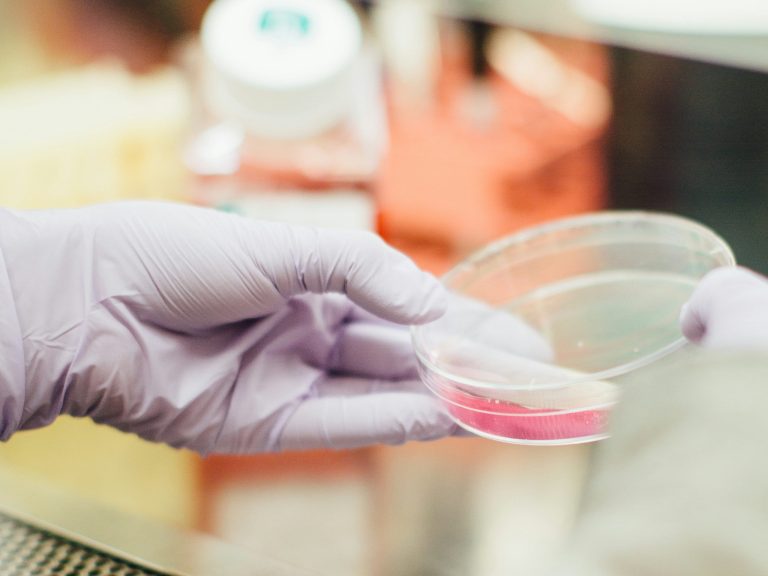

Avances en Investigación y Tecnología
Bienvenidos a la página web dedicada especialmente al seguimiento y difusión de cualquier avance científico relacionado con el gen KDM6B (JMJD3). Nuestro objetivo es compartir, apoyar e impulsar investigaciones mediante IA que ayuden a corregir parcial o totalmente los efectos de esta particular mutación
Welcome
Welcome to the website specifically dedicated to tracking and sharing any scientific advancements related to the KDM6B (JMJD3) gene. Our goal is to share, support, and promote research using AI to partially or fully correct the effects of this particular mutation.
Nuestra Misión
Comprometidos con el Futuro
Impulsando el Conocimiento Científico
El gran desafío de este proyecto es lograr que la desmetilasa de histonas KDM6B (JMJD3) llegue de forma funcional a las células de Lara, para restaurar el equilibrio epigenético alterado.”
“The major challenge of this project is to successfully deliver the histone demethylase KDM6B (JMJD3) into Lara’s cells, in order to restore the disrupted epigenetic balance

1
Investigación BASE - Stolerman
0
Colaboraciones Internacionales
2
Publicaciones Científicas
Destacados
Cutting-edge Research with Genetics-specialized AI
Our mission is to open a radically new path: combining state-of-the-art hardware (specialized GPUs, TPUs, emerging quantum accelerators) with multimodal AI agents capable of integrating genomics, epigenomics, and transcriptomics in real time. This synergy is not just about interpreting data, but about generating novel therapeutic hypotheses, simulating at the molecular scale how to restore the lost activity of the KDM6B (JMJD3) demethylase. From designing safer oligonucleotides and CRISPR vectors to developing mRNA-based strategies that rescue function in neural cells, AI acts as an autonomous co-scientist, exploring millions of possibilities and prioritizing the most viable ones. Ultimately, this is not an abstract research exercise, but a vital challenge: to ensure that the enzyme Lara lost can finally reach her cells and restore the epigenetic balance that should never have been broken.
Investigación de vanguardia con IA especializada en genética
Nuestro objetivo es abrir un camino radicalmente nuevo: combinar hardware de vanguardia (GPUs especializadas, TPUs, aceleradores cuánticos emergentes) con agentes de inteligencia artificial multimodales capaces de integrar genómica, epigenómica y transcriptómica en tiempo real. Esta sinergia no busca solo interpretar datos, sino generar hipótesis terapéuticas inéditas, simulando a escala molecular cómo restaurar la actividad perdida de la desmetilasa KDM6B (JMJD3). Desde el diseño de oligonucleótidos y vectores CRISPR más seguros, hasta estrategias de ARNm que rescaten la función en células neurales, la IA actúa como un co-científico autónomo que explora millones de posibilidades y prioriza las más viables. En última instancia, no se trata de una investigación abstracta, sino de un desafío vital: lograr que la enzima que Lara perdió llegue a sus células y le devuelva el equilibrio epigenético que nunca debió romperse.

Últimos Estudios
Presentamos investigaciones recientes sobre el gen KDM6B y sus implicaciones en la salud.
Innovaciones Tecnológicas
Implementamos nuevas tecnologías que apoyan a personas con mutaciones genéticas.

Colaboraciones
Colaboramos con diversas instituciones para potenciar el alcance de nuestra investigación.

Publicaciones
Acceda a publicaciones científicas que reflejan nuestras investigaciones y hallazgos.
Ponte en contacto
Correo electrónico: contact@genial.org.es
Dirección: Poligono Industrial Parcela T, nave Q-1b, Itziar, 20829, Guipúzcoa, Spain